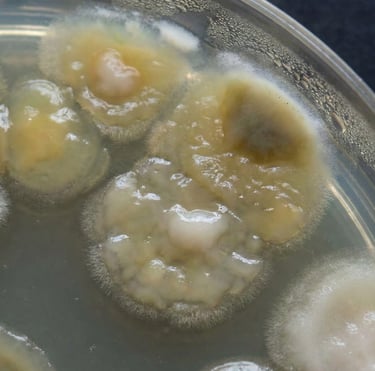
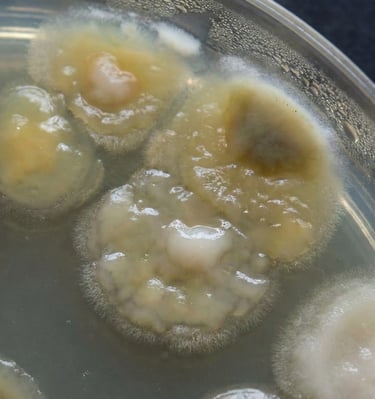

Next Level Cap Care: The Dishwasher Method You Need To Try
Brush out dirt and stains before putting in dishwasher

Magnified bacteria and germ build-up.
Bacteria and Germs thrive on baseball caps in warm, moist areas where sweat, oils, and dead skin cells collect, primarily in the inner lining, but also the fabric itself, creating ideal breeding grounds for bacteria, fungus, and mold, leading to odors, skin irritation, or dandruff if not cleaned regularly.
Bacteria and Germ Build-up
Know the Facts
This is why we created the first ever Dishwashing Detergent Sheets formulated specifically to remove odors, bacteria and germs from sweaty ball caps.
Photo Gallery












CLNcap
The bacteria, germ free solution
Contact
Newsletter
info@clncap.com
619-423-5702
© 2026. All rights reserved.
